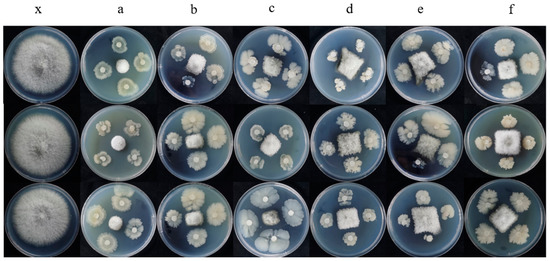

Abstract
Sorghum bicolor is cultivated worldwide. Leaf spot of sorghum, which leads to leaf lesions and yield reduction, is a prevalent and serious disease in Guizhou Province, southwest China. In August 2021, new leaf spot symptoms were observed on sorghum leaves. In this study, traditional methods and modern molecular biology techniques were used to isolate and identify the pathogen. Sorghum inoculated with the isolate GY1021 resulted in reddish brown lesion that similar to symptoms observed in the field: the original isolate inoculated was reisolated and Koch’s postulates were fulfilled. Based on morphological features and phylogenetic analysis of the internal transcribed spacer (ITS) combined sequence with β-tubulin (TUB2) and translation elongation factor 1-α (TEF-1α) genes, the isolate was identified as Fusarium thapsinum (Strain accession: GY 1021; GenBank Accession: ITS (ON882046), TEF-1α (OP096445), and β-TUB (OP096446)). Then, we studied the bioactivity of various natural products and microorganisms against F. thapsinum using the dual culture experiment. Carvacrol, 2-allylphenol, honokiol, and cinnamaldehyde showed excellent antifungal activity, with EC50 values of 24.19, 7.18, 46.18, and 52.81 µg/mL, respectively. The bioactivity of six antagonistic bacteria was measured using a dual culture experiment and the mycelial growth rate method. Paenibacillus polymyxa, Bacillus amyloliquefaciens and Bacillus velezensis displayed significant antifungal effects against F. thapsinum. This study provides a theoretical basis for the green control of leaf spot of sorghum.
1. Introduction
Sorghum bicolor is the fifth-largest crop in the world with high nutritional value. Their seeds contain roughly 70% starch and 11% protein, and are rich in vitamins, minerals, and micronutrients [1]. Sorghum has a wide range of applications, including brewing, food processing, and feed. Sorghum has strong resistance to stress, such as drought, cold, salt and alkali [2]; furthermore, it is adapted to a wide range of soil types and pH. However, unscientific use of fungicides, large area monoculture, climatic changes, and other related factors induced the spread of diseases, which have great influence on sorghum yield. Leaf spot is one of the most damaging diseases. The disease is mainly to harm the leaves. The leaves at the beginning of the onset have irregular spots, and then the spots are expanded to induce severe necrosis, which reduces the yield and quality of the sorghum [3]. Leaf spot usually leads to be 12–55% economic loss of sorghum production [4].
There are many fungi which were reported be the pathogen of sorghum leaf spot disease, for example, Pestalotiopsis trachycarpicola [1], Alternaria spp. [5], and Curvularia spp. In 2018, planting area of sorghum was more than 600,000 ha with a production of approximately 290 million tons in China. At present, sorghum leaf spot disease has occurred frequently in major sorghum producing areas, and has tended to be worse each year in China, especially in Guizhou province. Carbendazim, tectol and benendazim are the most commonly used chemical fungicide to control leaf spot of sorghum [6]. However, the use of chemical fungicides not scientific and rational result residue, resistance, environmental pollution and other problems [7], Halko et al. indicated that benzimidazole fungicides residue in soil, Gabriel et al. determined residue levels of seven commonly used pesticides and suggested long-term exposure can still cause health risks. Lim et al. studied and reported that the benomyl metabolite carbendazim has reproductive toxicity, Younghae et al. found that if applied unscientifically, which can lead to fungicide resistance in F. fujikuroi [8,9,10]. In contrast, natural products, such as natural product and antagonistic microbes, have the advantages of low toxicity, cause no pollution, and do not easily lead to pesticide resistance.
Compared with chemical control, biological control is considered a safe and effective method in plant diseases controlling. In recent years, many scholars have reported that pathogens can be controlled by biological agents. These include Bacillus amyloliquefaciens, which could control Pectobacterium carotovorum in potatoes [11]: Yuan et al. found the biocontrol mechanism of Paenibacillus polymyxa [12], Ali et al. revealed the high potential of biocontrol in Paenibacillus polymyxa complex [13], Zhou et al. reported Bacillus velezensis which could control the tomato bacterial wilt disease [14], and Bacillus licheniformis PR2 which could control fungal diseases and increase production [15]. Nonetheless, there has been no research into the biological control of sorghum leaf spot. Meanwhile, as natural products are also safe and effective for controlling plant disease, many studies have examined natural products as potential substances for the control of plant diseases and a good number of natural products can control plant diseases. Liu et al. reported that carvacrol could control vegetable diseases [16]. Qu et al. studied and found that 2-allylphenol showed excellent bioactivity against several plant pathogens [17], Oufensou et al. reported that honokiol had a strong antifungal effect against Fusarium [18]. It is reported that cinnamaldehyde can inhibit F. sambucinum ergosterol biosynthesis [19]. Mo et al. indicated that natural products magnolol is active against Rhizoctonia solani, and its mechanism lies in the destruction of the plasma membrane [20].
Liquor making is one of the oldest industries in the world [21]. At present, organic sorghum is used as the main raw material for liquor making in China. In addition, with the development of the national economy, the demand for organic sorghum has increased. Therefore, high-quality organic sorghum is urgently needed by brewing enterprises, and there is a need to develop efficient, safe, green, and sustainable prevention and control measures. Given the above situation, the causative pathogen of sorghum leaf spot disease was isolated and identified, then we screened biocontrol bacteria (Paenibacillus polymyxa, Bacillus velezensis, Bacillus amyloliquefaciens, Bacillus subtilis, Bacillus megaterium, and Bacillus licheniformis) and natural products with the potential to prevent and control sorghum leaf spot disease. In this study, our aim was to provide a “green” management method against sorghum leaf spot disease. Therefore, we explored the pathogens of sorghum leaf spot disease and screened the potential Bacillus spp. and natural fungicidal agents. This study offers new biological control resources against Fusarium thapsinum.
2. Materials and Methods
2.1. Pathogens, Antagonistic Strains, and Natural Products
The leaves of sorghum were collected (Table 1) and soaked in 75% alcohol for 30 s, disinfected with 10% sodium hypochlorite for 1–2 min, cleaned with sterile water thrice, drained with sterile paper, and dried in sterile Petri dishes. The dried symptomatic tissues were then transferred to potato dextrose agar (PDA: 200.0 g potato, 20.0 g glucose, 17.0 g agar/L) plates on an ultra-clean workbench and cultured in a biochemical incubator (Ningbo Jiangnan Instrument Co., Ltd., Zhejiang, China) at 25 °C. After incubation at 25 °C for 48 h, a single colony was transferred to new plates, incubated at 25 °C for 5 days. The single colony was soaked in 30% glycerol and stored at −80 °C. Then, according to Koch’s postulates, isolates were inoculated on sorghum leaves, and re-isolated and purified. Paenibacillus polymyxa Y-1, Bacillus velezensis MT310, Bacillus amyloliquefaciens MT323, Bacillus subtilis MT332, Bacillus megatherium L2, Bacillus licheniformis MTQ23 all are from the College of Agriculture, Guizhou University. Natural products (eugenol, magnolol, thymol, cinnamaldehyde, honokiol, carvacrol, 2-allylphenol) with purities of ≥98% were purchased from Aladdin Reagent Co., Ltd. (Shanghai, China) and stored at 2–8 °C.

Table 1.
Source of symptomatic leaves.
2.2. Pathogenicity Assays
Five fungal strains were isolated for Koch’s hypothesis [22]. The fungal isolates were incubated in potato dextrose broth (PDB; 200.0 g potatoes infusion, 20.0 g glucose, 1 L water), in 120 rpm and 25 °C shakers for 5 d, then, conidia were collected by filtering through gauze. Then, a concentration of 1 × 106 conidia/mL was collected with a hemocytometer and spray 500 μL evenly with a sterile watering can on healthy sorghum leaves. 500 μL of sterile distilled water was sprayed as a blank control. The inoculated sorghum was placed in an incubator under 28 °C, 85% RH and 12/12 h light/dark, and occurrence of disease was regularly observed with phytopathometric assessments. Experiments were performed in triplicate.
2.3. Pathogen Identification
The identification of pathogens usually includes both morphology and molecular biology. The morphology of the mycelia and fungal spores incubated at 28 °C for 10 days was observed using an optical microscope (LEICA ICC50 W, Leica Microsystems Co., Ltd., Shanghai, China). Morphological identification of the isolates was performed [23]. Fungal DNA was extracted from fresh aerial mycelia grown on PDA plates using a Fungal Genomic DNA Kit (Tiangen Biotech (Beijing, China) following the manufacturer’s instructions. Universal primers targeting ITS, TEF-1α, and β-TUB genes (Table 2) were used in polymerase chain reaction (PCR) program following Watanabe’s method [24]. DNA amplification was performed in a final volume of 25 μL containing 12.5 μL of 2×Taq Master Mix (Sangong Bioengineering Co., Ltd. (Shanghai, China), 10 μM of each forward and reverse primer, 100 ng of DNA template, and ddH2O. The amplified PCR products were sequenced by Sangon Biotech Co., Ltd. (Shanghai, China). Then a polygene phylogenetic tree was constructed using the maximum likelihood (ML) method in MEGA 7.0 [25] software with bootstrap values based on 1000 replications. F. delphinoides CBS 110140 was used as an outgroup.

Table 2.
PCR primers for ITS, TEF-1α, and β-TUB gene amplification.
2.4. Antagonistic Bacteria Screening
The antagonistic bacteria were tested in vitro for the inhibition effect against F. thapsinum [27]. A 5 mm disc from the edge of colony was transferred to the center of the PDA plate. Then, 0.5 cm circles were punched into the filter paper and soaked in the antagonistic strains. The antagonistic strains were inoculated at four symmetrical points 20 mm away from the F. thapsinum. The control inoculated 0.5 cm filter paper circles with sterile distilled water at four symmetrical points located 20 mm from the pathogen. All plates were incubated for 5 days under 28 °C. The mycelial growth inhibition rate was calculated according to formula: A = (m1 − m2)/m1 × 100, where A is mycelia growth inhibition rate, m1 is the hyphae area of the control, m2 is the hyphae area of the treated [28]. All experiments were repeated three times.
2.5. Antifungal Activity of Aseptic Filtrate from Antagonistic Bacteria against GY 1021
The inhibition effect of aseptic filtrate on the mycelial growth of F. thapsinum was assessed according [29]. An amount of 1 mL of antagonistic bacteria with OD (optical density) = 0.6 was transferred to a 0.25 L flask with 0.1 L nutrient agar broth (NA). The conical flasks sealed with parafilm were incubated in a rotary shaker (150× g at 37 °C). After 48 h of incubation, bacterial solution was filtered using a sterile filter gauze, followed by filtration through a 0.44 µm and a 0.22 µm membrane filter, then, aseptic filtrate was obtained. In addition, the sterile filtrate was added to the medium to concentrations of 25 mL L−1, 50 mL L−1, and 100 mL L−1, respectively, the medium was added to plates, after the medium became cool and solidify, the pathogen discs were inoculated to the center of PDA plates containing. After incubation under 25 °C for 7 days, the colony diameter was measured using the “ten” crossing method. All experiments repeated three times. Adding sterile water was used as a control. The inhibitory rate was calculated according: inhibitory rate (%) = [(dcontrol − dtreatment)/dcontrol] × 100 [30], d is the diameter of the F. thapsinum colony.
2.6. Antimicrobial Activity of Natural Products on Mycelial Growth
The antifungal activity of natural products was determined by mycelium growth rate method [31], different natural products were dissolved in appropriate organic solvents (2-allylphenol and eugenol in ethanol, honokiol in dimethyl sulfoxide, cinnamaldehyde, carvacrol, and magnolol in acetone, thymol in sterile water, all solvents have a concentration greater than 99%) and then, using water, mixed evenly with the PDA medium at different concentrations. The control contains the corresponding solvent. After incubation for 7 days at 25 °C, the colony diameter was measured using the "ten" crossing method. The EC50 (concentration for 50% of maximal effect) values of different natural antifungals were calculated using IBM SPSS analytics (SPSS Inc., Chicago, IL, USA) [20]. Each treatment was conducted with three replicates.
2.7. Effects of Aseptic Filtrate and Natural Products on Controlling Sorghum Leaf Spot Disease
Four holes were punctured using a sterile syringe at suitable locations in the sorghum leaves. Then, different antagonistic bacteria of aseptic filtrate (100 mL L−1) were sprayed on each leaf, and three natural products (2-allylphenol, carvacrol, honokiol) were formulated at 7, 24, and 46 mg/L, respectively, and the liquid medicine was sprayed evenly on each leaf. An amount of 1 × 106 conidia/mL was inoculated at the site of the stab wound. Subsequently, the plants were placed in a sterile crisper, placed into greenhouses, and maintained under a fixed photoperiod (12 h light, 12 h dark) at 28 °C and 80% relative humidity. After incubation for 7 days, the lesion area was measured using ImageJ software (National Institute of Health, Bethesda, MD, USA). The disease incidence (%) was calculated using the formula: (M1 − M2)/M1 × 100, where M1 and M2 represent the decayed areas in the treatment group and control group, respectively. Experiments were performed in triplicate.
2.8. Statistical Analyses
All statistical data analyses were performed using Excel 2021. One-way ANOVA was performed as per Duncan’s multiple range test to determine the significance of differences (p < 0.05 were considered significant). Charts were plotted with Origin 2021 and DPS.
3. Results
3.1. Isolation of the Pathogen and Pathogenicity Assays
The diseased leaves were found in a sorghum plantation in Huaxi County, the diseased leaves showed red necrotic spots and irregular lesions on the leaves (Figure 1a). Five isolates were isolated and purified. The five isolates were inoculated on sorghum leaves: only the strain GY1021 caused spots, which was similar with the symptoms in the field, and the same fungi were reisolated. Pathogenicity results showed that 6 d after treatment with the strain GY1021 conidia suspension, red irregular spots appeared on the sorghum leaves and the leaf margins withered and shrunk (Figure 1b,c), after 10 days, the lesion became gray and the whole leaf withered (Figure 1c). Figure 1d is control. The leaves inoculated with sterile distilled water did not show leaf spot symptoms. The same strains were isolated from diseased leaves and satisfied Koch’s hypothesis.

Figure 1.
Natural field symptoms of sorghum leaf disease (a); Symptoms 6 days after artificial inoculation (b); Symptoms 10 days after artificial inoculation (c); Control (d).
3.2. Morphological Identification and Molecular Identification of the Pathogen
According to the morphological characteristics of colony, the pathogen was identified as Fusarium spp. The characteristics of the colony of Fusarium species are shown in Figure 2, and the shape land septum of macroconidia are also described as shown. The Fusarium colonies grew quickly (0.76 mm d−1 at 28 °C) and were usually white or yellow in appearance with developed aerial mycelia. The new colonies cultured on PDA were white, whereas the old colonies cultured for 5 days were yellow in the middle with a white fringe (Figure 2A,B). Conidia were produced on water agar containing carnation leaf pieces, and the conidiogenous cells were phialidic. Under optical microscopy, the conidia appeared slightly curved, with blunt and occasionally hooked apical cells. There were many small conidia, and the large, mature conidia were usually three-septate and measured 29.32–43.89 µm × 3.63–5.52 µm.

Figure 2.
The morphology of pathogen grown on PDA medium for 5 days (A,B); conidiophores (D); the structure that produces conidia (C,E). Scale bar is 50 μm.
For phylogenic analysis, the phylogenetic tree was constructed by using the combined sequences of ITS, β-TUB and TEF-1α in MEGA 7.0 software with bootstrap values based on 1000 replications, as shown in Figure 3, including 1 species of Fusarium thapsinum, 18 other referred isolates of Fusarium species, and F. delphinoides was an outgroup species (Table 3). The sequences of representative isolates of ITS, TUB2, and TEF-1α were aligned with the corresponding sequences of different species of Fusarium obtained from NCBI’s GenBank nucleotide database.

Figure 3.
The ITS–TEF-1α–TUB2 phylogenetic tree.

Table 3.
Reference isolates used in this study and their GenBank accession numbers.
To identify the strain GY 1021, the sequences of the ITS (557), tef (694), and β-tub (974) were amplified by PCR and then submitted to GenBank database with the accession numbers of ITS (ON882046), tef-1α (OP096445), and β-tub (OP096446), respectively. The consequences of BLAST displayed that the ITS sequence of the strain GY 1021 had 100% identity with Fusarium thapsinum (KR071692), the tef-1α sequence of strain GY 1021 had 100% identity with Fusarium thapsinum (MW401962), and the β-tub sequence of strain GY 1021 had 100% identity with Fusarium thapsinum (MW402222). The maximum likelihood (ML) method in MEGA 7.0 software was used to construct a multigene phylogenetic tree. Phylogenetic analysis further demonstrated that strain GY 1021 was clustered with Fusarium thapsinum (Figure 3). Through detailed morphological studies and phylogenetic tree construction, strain GY1021 was finally identified as Fusarium thapsinum. Note: GY 1021 is the pathogen (F. thapsinum). F. delphinoides(CBS 110140) is outgroup.
3.3. Screening of Antagonistic Strains
The results of dual culture experiment displayed that Paenibacillus polymyxa have strong inhibitory activity against F. thapsinum. The best inhibitory effect was obtained with Paenibacillus polymyxa, and the inhibitory effect on mycelial growth was approximately 82.12% (Figure 4), the inhibitory rates of Bacillus amyloliquefaciens, Bacillus velezensis, Bacillus subtilis, Bacillus megaterium, and Bacillus licheniformis was 77.05%, 69.70%, 61.07%, 61.67%, and 64.56%, respectively.
Figure 4.
The antagonistic bacteria were tested in vitro for the inhibitory effect against F. thapsinum. (a) Paenibacillus polymyxa; (b) Bacillus velezensis; (c) Bacillus amyloliquefaciens; (d) Bacillus subtilis; (e) Bacillus megaterium; (f) Bacillus licheniformis; (x) Control.
3.4. Effects of Aseptic Filtrate on the Mycelial Growth of F. thapsinum
The inhibitory effect of the aseptic filtrate on F. thapsinum were detected in vitro (Table 4). The results indicated that the antibacterial activity increased with the increase in the concentration of sterile filtrate. The mycelial growth of F. thapsinum was significantly suppressed by aseptic filtrate of Bacillus amyloliquefaciens, Paenibacillus polymyxa, Bacillus velezensis, Bacillus subtilis, Bacillus licheniformis, and Bacillus megaterium, with inhibition rates of 61.70% ± 0.40%, 57.91% ± 0.40%, 49.87% ± 0.23%, 44.44% ± 0.23%, 43.49% ± 0.77%, and 41.60% ± 0.23%, respectively. The aseptic filtrate of Bacillus amyloliquefaciens resulted in the greatest inhibition of F. thapsinum.

Table 4.
In vitro inhibitory activity.
3.5. Antifungal Activity of Natural Products on Mycelium
The screening of antifungal activity in natural products against F. thapsinum strain is conducive to the development of green, low-toxicity fungicides. The results of the sensitivity testing of seven natural products agents on F. thapsinum are shown in Table 5. 2-allylphenol had significant antifungal activity, with an EC50 value of 7.18 ± 0.02 µg/mL, followed by carvacrol, honokiol, cinnamaldehyde, magnolol, and eugenol with EC50 values of 24.19 ± 0.49, 46.18 ± 0.60, 52.81 ± 0.30, 75.78 ± 0.22, and 82.39 ± 0.17 µg/mL, respectively. Thymol antibacterial activity was poor, with an EC50 value of 92.84 ± 0.51 µg/mL. When examining the regression equations, the slope of 2-allylphenol was the largest, at 2.4329, and that of thymol was the smallest, at 1.3692. This indicated that F. thapsinum was most sensitive to 2-allylphenol and least sensitive to thymol.

Table 5.
Antimicrobial activity of natural products.
3.6. Effects of Aseptic Filtrate and Natural Products on Controlling Sorghum Leaf Spot Disease
To confirm the effect of the aseptic filtrate and natural products on F. thapsinum in vivo, the aseptic filtrate of Bacillus amyloliquefaciens, Bacillus velezensis, Paeni Bacillus polymyxa, and the natural products 2-allylphenol, carvacrol, and honokiol were used to alleviate the severity of sorghum decay caused by F. thapsinum (Figure 5). AF (aseptic filtrate); NA (natural antifungal agent). Bacillus amyloliquefacien, Bacillus velezensis, and Paenibacillus polymyxa are all at 100 mL L−1, 2-allylphenol, carvacrol, and honokiol are 7, 24, and 46 mg L−1, respectively. Disease inhibition rate was measured after treatment with three antagonistic bacteria aseptic filtrates and three natural products. After 15 days, the spots were measured. The disease inhibition rates were 78.97%, 55.62%, and 69.51% for Bacillus amyloliquefaciens, Bacillus velezensis, and Paenibacillus polymyxa, respectively, and the disease inhibition rates were 87.29%, 85.23%, and 80.13% for 2-allylphenol, carvacrol, and honokiol, respectively. Bacillus amyloliquefaciens, Paenibacillus polymyxa, 2-allylphenol, carvacrol, and honokiol have significant inhibitory effects (Figure 6). The lesion area was measured using ImageJ software (National Institute of Health, Bethesda, MD, USA).

Figure 5.
In vivo antifungal effects of aseptic filtrate and natural products on disease extension in sorghum caused by F. thapsinum. (A) (Bacillus amyloliquefaciens), (B) (Bacillus velezensis), (C) (Paenibacillus polymyxa), (D) (2-allylphenol), (E) (carvacrol), (F) (honokiol), (T1) (control).

Figure 6.
In vivo effect of aseptic filtrate and natural products on disease extension in sorghum leaf spot disease caused by F. thapsinum. Data are displayed as the mean ± SE. According to Duncan’s multiple range test. The same lowercase letters represent no significant difference between treatments (p < 0.05).
4. Discussion
Sorghum planting has a long history and a wide range of regions. It is a very important raw material for grain, feed crops, as well as winemaking and vinegarmaking. However, sorghum is susceptible to various pathogens during the processes of cultivation, transportation, and storage, resulting in a serious decline in the quality of sorghum and enormous economic losses. Diseases reported so far include anthrax [32], leaf spot, and stem rot; stem rot was caused by F. thapsinum, Pestalotiopsis trachycarpicola [3]. Fusarium thapsinum is a common and highly pathogenic pathogen. At present, the application of chemical fungicides is still the main measure to control sorghum diseases. However, long-term application of chemical pesticides will endanger food safety and destroy environment. Accordingly, it is particularly necessary to search green and effective measures to control sorghum diseases. Biological control can promote crop growth, increase beneficial microbial populations, and effectively control crop diseases [31]. Therefore, the study of natural products and biological means to control sorghum diseases is of great significance. In general, natural products control the occurrence and prevalence of diseases by inhibiting the growth and reproduction of pathogens. Wei et al. found that cinnamaldehyde first significantly affects the integrity of the cell membrane of Fusarium sambucinum, and then reduces the mitochondrial membrane potential and induces the accumulation of reactive oxygen species in cells [19]. At the same time, cinnamaldehyde can reduce ergosterol content. The results of Mo et al. showed that honokiol can significantly damage the plasma membrane of R. solani, and interfere with cell respiratory metabolism, thus inhibiting the growth of mycelium [20]. Microbial antagonists control disease by competing with pathogens for nutrients and space; nonpathogenic Fusarium cereus competes with pathogenic Fusarium dysphoria to inhibit blight by competing for nutrients such as carbon and iron [33]. Kalantarl et al. confirmed that a mixture of Bacillus, Pseudomonas, and Rhizobia had a synergistic effect, producing a variety of beneficial substances that could effectively inhibit blight root rot and increase soybean yield [34]. The research data of Azaiez et al. showed that protection against potato soft rot disease may be related to glycolipid production by Bacillus amyloliquefaciens [11]. Bacillus velezensis can both individually promote tomato plant growth, increase leaf chlorophyll content, enhance defensive enzyme activities, and induce the accumulation of D-fructose and D-glucose [14].
In this study, a pathogen of sorghum leaf disease was isolated, F. thapsinum, from sorghum “hongyingzi”. Currently, there are almost no report of the effect of F. thapsinum on sorghum; however, its impact cannot be ignored, and prevention measures should be taken in time. Presently, chemical control is the main measure to prevent and treat diseases caused by F. thapsinum. Chemical fungicides agents could effectively control plants diseases; however, unreasonable application of chemical fungicides can result in pathogens resistance [35]. In contrast, biocontrol bacteria agents and natural products have attracted more and more attention because they are in line with the European IPM framework and organic agriculture legislation while improving the sustainability of agricultural operations [36]. Therefore, we screened natural products and biocontrol bacteria. The study results show that these natural products and biocontrol bacteria could effectively inhibit the growth of F. thapsinum. However, the effect of natural products was notably better than that of aseptic filtrates. There are several possible explanations for this: (1) There are defects in the preparation method of aseptic filtrates that should be improved. (2) The aseptic filtrate has a low content of active ingredients and may need to be concentrated. (3) The antibacterial components of the aseptic filtrate may be volatilized or decomposed. Natural products and biocontrol bacteria have significant inhibitory effects on F. thapsinum; however, their success in controlling the sorghum disease caused by F. thapsinum still needs to be verified by field experiments. The antibacterial mechanism of these natural products and some biocontrol bacteria is not clear; thus, further study is required.
5. Conclusions
In this study, a new pathogen GY 1021 causing leaf spot of sorghum was isolated from sorghum “Hongyingzi,” and was identified as F. thapsinum. Simultaneously, we screened the inhibitory effects of seven natural products on F. thapsinum, 2-allylphenol, carvacrol, and honokiol were found to have the potential to inhibit the growth of mycelium, in vitro, F. thapsinum was most sensitive to 2-allylphenol. In the screening of six biocontrol bacteria, Paenibacillus polymyxa was found to be the most effective antifungal agent against F. thapsinum. The aseptic filtrate of Paenibacillus polymyxa caused the highly inhibition of F. thapsinum. Honokiol, 2-allylphenol, carvacrol and the aseptic filtrate of Paenibacillus Polymyxa could effectively inhibit the spots extension. This study has certain reference value for the prevention and control of sorghum leaf diseases.
Author Contributions
Conceptualization, G.W. and A.H.; methodology, G.W. and M.R.; formal analysis, H.X. and Y.H.; investigation, W.Z. and G.W.; data curation, W.Z. and G.W.; writing—original draft preparation, G.W.; writing—review and editing, H.X. and A.H.; supervision, A.H.; funding acquisition, A.H.; Software, W.Z.; All authors have read and agreed to the published version of the manuscript.
Funding
This research was funded by Guizhou Province High-level Innovative Talent Project: GCC [2022]027-1 and Guizhou Provincial Department of Finance, Guizhou Provincial Department of Industry and Information Technology (Qian CAI Gong [2020]198).
Institutional Review Board Statement
Not applicable.
Informed Consent Statement
Not applicable.
Data Availability Statement
The datasets generated and/or analyzed during the study are available from the corresponding author upon reasonable request.
Conflicts of Interest
The authors declare no conflict of interest.
References
- Gerrano, A.S.; Labuschagne, M.T.; van Biljon, A.; Shargie, N.G. Quantification of Mineral Composition and Total Protein Content in Sorghum [Sorghum Bicolor (L.) Moench] Genotypes. Cereal Res. Commun. 2016, 44, 272–285. [Google Scholar] [CrossRef]
- Prasad, V.B.R.; Govindaraj, M.; Djanaguiraman, M.; Djalovic, I.; Shailani, A.; Rawat, N.; Singla-Pareek, S.L.; Pareek, A.; Prasad, P.V.V. Drought and High Temperature Stress in Sorghum: Physiological, Genetic, and Molecular Insights and Breeding Approaches. Int. J. Mol. Sci. 2021, 22, 9826. [Google Scholar] [CrossRef]
- Fan, J.; Qiu, H.B.; Long, H.J.; Zhao, W.; Hu, A.L. First report of leaf spot on sorghum caused by pestalotiopsis trachycarpicola in china. Plant Pathol. 2021, 103, 1043–1044. [Google Scholar] [CrossRef]
- Yang, S.Y.; Feng, M.C.; Lu, J.; Zhang, H.Z.; Fan, J.; Zhao, W.; Hu, A. Bioactivity of 8 natural productagainst pathogen of sorghum leaf spot. World J. Agric. Med. 2021, 43, 53–57. [Google Scholar]
- Zhao, Y.Q.; Yu, H.R.; Shi, K.; Zhang, D.M.; Zhu, P.T.; Cai, C.; Jia, A.M. Pathogen identification of sorghum Alternaria alternaria leaf spot disease. Chin. J. Plant Pathol. 2017, 47, 282–285. [Google Scholar]
- Wang, C.L. The occurrence and prevention of major diseases of sorghum in Heilongjiang Province. Chin. Mod. Agricl. Sci Technol. 2018, 17, 119–123. [Google Scholar]
- Xue, Y.; Yang, Z.R.; Huang, X.B.; Xu, J.G. Properly handle the "3R" problem to ensure the quality and safety of agricultural products. Hubei Prov. Plant Prot. 2017, 6, 60–62. [Google Scholar]
- Halko, R.; Sanz, C.P.; Ferrera, Z.S.; Rodríguez, J.J.S. Determination of benzimidazole fungicides in soil samples using microwave-assisted micellar extraction and liquid chromatography with fluorescence detection. J. AOAC Int. 2006, 89, 1403–1409. [Google Scholar] [CrossRef]
- Lim, J.; Miller, M.G. The role of the benomyl metabolite carbendazim in benomyl-induced testicular toxicity. Toxicol. Appl. Pharmacol. 1997, 142, 401–410. [Google Scholar] [CrossRef]
- Younghae, C.; Boknam, J.; Li, T.; Jungkwan, L. Identification of genes related to fungicide resistance in fusarium fujikuroi. Mycobiology 2017, 45, 101–104. [Google Scholar]
- Azaiez, S.; Slimene, I.B.; Karkouch, I.; Essid, R.; Jallouli, S.; Djebali, N.; Elkahoui, S.; Limam, F.; Tabbene, O. Biological Control of the Soft Rot Bacterium Pectobacterium carotovorum by B. amyloliquefaciens Strain Ar10 Producing Glycolipid-like Compounds. Microbiol. Res. 2018, 217, 23–33. [Google Scholar] [CrossRef]
- Yuan, H.; Yuan, M.; Shi, B.; Wang, Z.; Huang, T.; Qin, G.; Hou, H.; Wang, L.; Tu, H. Biocontrol activity and action mechanism of PaeniB. polymyxa strain Nl4 against pear Valsa canker caused by Valsa pyri. Front. Microbiol. 2022, 13, 950742. [Google Scholar] [CrossRef]
- Ali, M.A.; Lou, Y.; Rahila, H.; Li, X.Q.; Afsana, H.; Xie, T.; Lin, L.; Li, B.; Yin, Y.N.; Yan, J.L.; et al. Functional Analysis and Genome Mining Reveal High Potential of Biocontrol and Plant Growth Promotion in Nodule-Inhabiting Bacteria Within Paenibacillus polymyxa Complex. Front. Microbiol. 2021, 11, 618601. [Google Scholar] [CrossRef]
- Zhou, Y.; Yang, L.; Wang, J.; Guo, L.; Huang, J. Synergistic Effect between Trichoderma virens and Bacillus velezensis on the Control of Tomato Bacterial Wilt Disease. Horticulturae 2021, 7, 439. [Google Scholar] [CrossRef]
- Kwon, J.-H.; Won, S.-J.; Moon, J.-H.; Lee, U.; Park, Y.-S.; Maung, C.E.H.; Ajuna, H.B.; Ahn, Y.S. Bacillus licheniformis PR2 Controls Fungal Diseases and Increases Production of Jujube Fruit under Field Conditions. Horticulturae 2021, 7, 49. [Google Scholar] [CrossRef]
- Liu, Q.; Qiao, K.; Zhang, S. Potential of a Small Molecule Carvacrol in Management of Vegetable Diseases. Molecules 2019, 20, 1932. [Google Scholar] [CrossRef] [PubMed]
- Qu, T.; Gao, S.; Li, J.; Hao, J.J.; Ji, P. Synthesis and antifungal activity of 2-allylphenol derivatives against fungal plant pathogens. Pestic. Biochem. Physiol. 2017, 135, 47–51. [Google Scholar] [CrossRef] [PubMed]
- Oufensou, S.; Scherm, B.; Pani, G.; Balmas, V.; Fabbri, D.; Dettori, M.A.; Carta, P.; Malbrán, I.; Migheli, Q.; Delogu, G. Honokiol, magnolol and its monoacetyl derivative show strong anti-fungal effect on Fusarium isolates of clinical relevance. PLoS ONE 2019, 14, e0221249. [Google Scholar] [CrossRef] [PubMed]
- Wei, J.; Bi, Y.; Xue, H.; Wang, Y.; Zong, Y.; Prusky, D. Antifungal activity of cinnamaldehyde against Fusarium sambucinum involves inhibition of ergosterol biosynthesis. J. Appl. Microbiol. 2020, 129, 256–265. [Google Scholar] [CrossRef]
- Mo, F.; Hu, X.; Ding, Y.; Li, R.; Li, M. Naturally produced magnolol can significantly damage the plasma membrane of Rhizoctonia solani. Pestic. Biochem. Physiol. 2021, 178, 104942. [Google Scholar] [CrossRef]
- Cristina, M.; António, P. Water to wine in wineries in Portugal Douro Region: Comparativestudy between wineries with different sizes. Sci. Total Environ. 2020, 732, 139332. [Google Scholar]
- Li, H.H.; Tang, W.; Liu, K.; Zhang, L.; Tang, X.F.; Miao, M.; Liu, Y.S. First Report of Fusarium fujikuroi Causing Brown Leaf Spot on Kiwifruit. Plant Dis. 2020, 104, 1560–1561. [Google Scholar] [CrossRef]
- Xu, H.; Yan, L.; Zhang, M.; Chang, X.; Zhu, D.; Wei, D.; Naeem, M.; Song, C.; Wu, X.; Liu, T.; et al. Changes in the Density and Composition of Rhizosphere Pathogenic Fusarium and Beneficial Trichoderma Contributing to Reduced Root Rot of Intercropped Soybean. Pathogens 2022, 11, 478. [Google Scholar] [CrossRef]
- Watanabe, M.; Yonezawa, T.; Lee, K.; Kumagai, S.; Sugita-Konishi, Y.; Goto, K.; Hara-Kudo, Y. Molecular Phylogeny of the Higher and Lower Taxonomy of the Fusarium Genus and Differences in the Evolutionary Histories of Multiple Genes. BMC Evol. Biol. 2011, 11, 322. [Google Scholar] [CrossRef]
- Liu, X.; Wang, X.; Sun, B.; Sun, L. The Involvement of Thiamine Uptake in the Virulence of Edwardsiella piscicida. Pathogens 2022, 11, 464. [Google Scholar] [CrossRef]
- Zhang, Y.; Chen, C.; Zhao, J.; Chen, C.; Lin, J.; Jayawardena, R.S.; Xiang, M.; Manawasinghe, I.S.; You, C. Fusarium elaeidis causes stem and root rot on Alocasia longiloba in south China. Pathogens 2021, 10, 1395. [Google Scholar] [CrossRef] [PubMed]
- Yan, F.; Li, C.; Ye, X.; Lian, Y.; Wu, Y.; Wang, X. Antifungal Activity of Lipopeptides from B. amyloliquefaciens MG3 against Colletotrichum gloeosporioides in Loquat Fruits. Biol. Control. 2020, 146, 104281. [Google Scholar] [CrossRef]
- Etebarian, H.-R.; Sholberg, P.L.; Eastwell, K.C.; Sayler, R.J. Biological Control of Apple Blue Mold with Pseudomonas fluorescens. Can. J. Microbiol. 2005, 51, 591–598. [Google Scholar] [CrossRef]
- Zheng, T.; Liu, L.; Nie, Q.; Hsiang, T.; Sun, Z.; Zhou, Y. Isolation, Identification and Biocontrol Mechanisms of Endophytic Bacterium D61-A from Fraxinus hupehensis against Rhizoctonia solani. Biol. Control. 2021, 158, 104621. [Google Scholar] [CrossRef]
- Li, W.; Long, Y.; Mo, F.; Shu, R.; Yin, X.; Wu, X.; Zhang, R.; Zhang, Z.; He, L.; Chen, T.; et al. Antifungal Activity and Biocontrol Mechanism of Fusicolla violacea J-1 against Soft Rot in Kiwifruit Caused by Alternaria alternata. J. Fungi. 2021, 7, 937. [Google Scholar] [CrossRef]
- Xin, W.; Mao, W.; Lu, F.; Li, T.; Wang, J.; Duan, Y.; Zhou, M. In vitro fungicidal activity and in planta control efficacy of coumoxystrobin against Magnaporthe oryzae. Pestic. Biochem. Physiol. 2020, 162, 78–85. [Google Scholar] [CrossRef] [PubMed]
- Acharya, B.; O’Quinn, T.N.; Everman, W.; Mehl, H.L. Effectiveness of fungicides and their application timing for the management of sorghum foliar anthracnose in the mid-atlantic u.s. Plant Dis. 2019, 103, 2804–2811. [Google Scholar] [CrossRef] [PubMed]
- Mazurier, S.; Corberand, T.; Lemanceau, P.; Raaijmakers, J.M. Phenazine Antibiotics Produced by Fluorescent pseudomonads Contribute to Natural Soil Suppressiveness to Fusarium wilt. ISME J. 2009, 3, 977–991. [Google Scholar] [CrossRef] [PubMed]
- Kalantari, S.; Marefat, A.; Naseri, B.; Hemmati, R. Improvement of Bean Yield and Fusarium Root Rot Biocontrol Using Mixtures of Bacillus, Pseudomonas and Rhizobium. Trop. Plant. Pathol. 2018, 43, 499–505. [Google Scholar] [CrossRef]
- Chen, T.; Wu, X.; Dai, Y.; Yin, X.; Zhao, Z.; Zhang, Z.; Li, W.; He, L.; Long, Y. Sensitivity Testing of Natural products on Fusarium fujikuroi to Investigate the Potential for Sustainable Control of Kiwifruit Leaf Spot Disease. J. Fungi 2022, 8, 239. [Google Scholar] [CrossRef] [PubMed]
- Lamichhane, J.R.; Dachbrodt-Saaydeh, S.; Kudsk, P.; Messéan, A. Toward a reduced reliance on conventional pesticides in European agriculture. Plant Dis. 2016, 100, 10–24. [Google Scholar] [CrossRef]
Disclaimer/Publisher’s Note: The statements, opinions and data contained in all publications are solely those of the individual author(s) and contributor(s) and not of MDPI and/or the editor(s). MDPI and/or the editor(s) disclaim responsibility for any injury to people or property resulting from any ideas, methods, instructions or products referred to in the content. |
© 2023 by the authors. Licensee MDPI, Basel, Switzerland. This article is an open access article distributed under the terms and conditions of the Creative Commons Attribution (CC BY) license (https://creativecommons.org/licenses/by/4.0/).